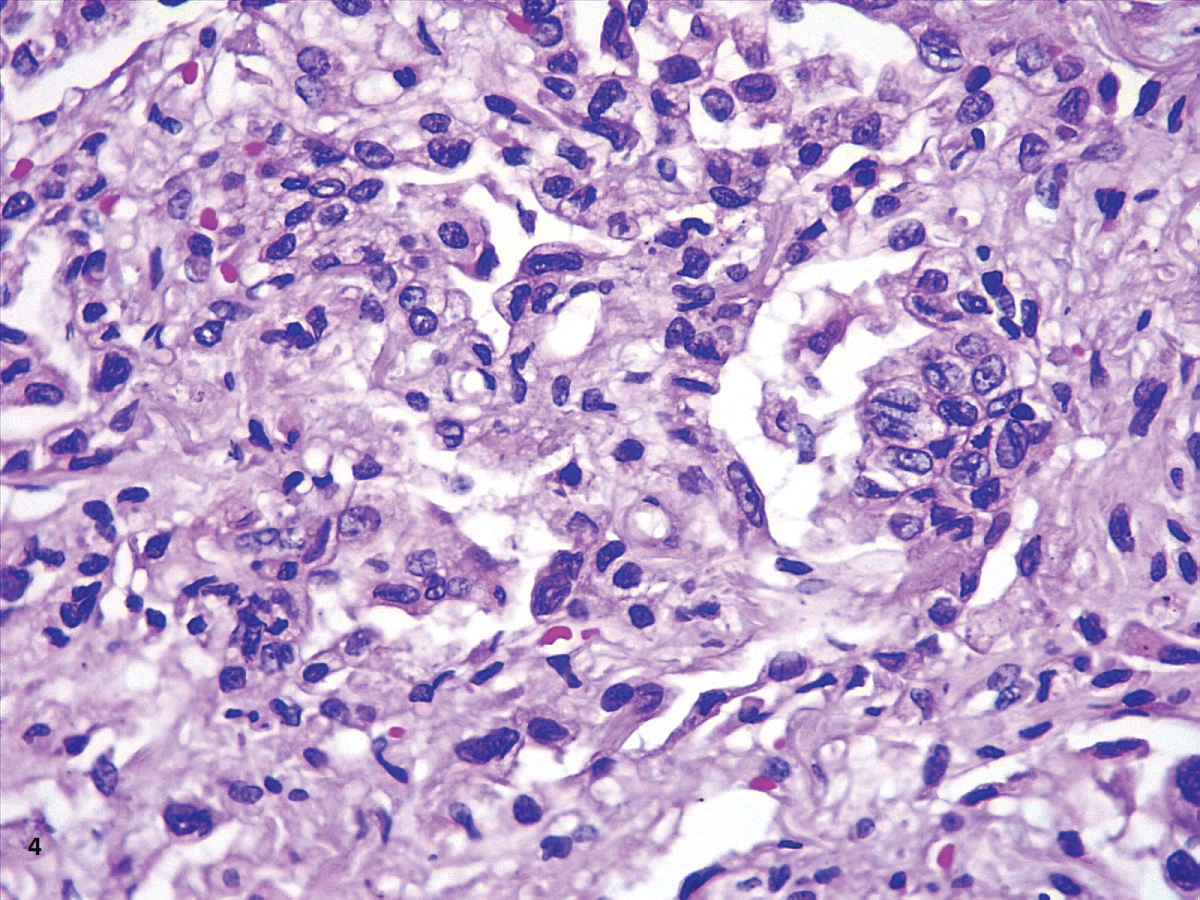

The COVID-19 epidemic has caused thousands of deaths all over the world. This virus is known to produce an atypical pneumonia that can lead to death. There are few studies concerning pathological examination of tissues from COVID-19 patients.
Objective: To describe the pathological findings in tissues from deceased patients with COVID-19 infection.
Design: We conducted a case series study with postmortem biopsies of lung, hearth and liver from 18 patients with COVID-19 and compared our findings with previously reported cases.
Results: Our main findings support the histologic picture of coexisting exudative and proliferative phases of diffuse alveolar damage (DAD), and the presence of cytopathic-like changes in the lungs. We also found an increased number of alveolar macrophages in patients with high ferritin values, which has not been previously described. 17/18 cases showed deposits of lipofuscin in the myocardium; which, we hypothesize that could be related to the treatment with hydroxychloroquine received in all patients. None of them had documented clinical evidence of cardiotoxicity. Findings in the liver were considered not specific and related to preexisting disease, therapeutic effect and/or systemic failure.
Conclusions: Our findings were congruent with previous reports; additionally, we found higher number of alveolar macrophages in patients with highest levels of ferritin and deposits of lipofuscin in all the hearts examined, most likely associated with hydroxychloroquine therapy.
COVID-19, SARS-CoV-2, Pneumonia, Autopsy, Diffuse alveolar damage, Acute lung injury, Acute respiratory distress syndrome, Heart, Liver, Coronavirus
The coronavirus-19 (COVID-19) pandemic has imposed a tremendous pressure on the medical community, who faces the challenge of treating critically ill patients while at the same time developing new knowledge about the pathogenesis, clinical presentation, treatment and prognostic factors of this disease. Since the beginning of the pandemic there has been a call to perform pathological studies for a better understanding of the disease [1] and recommendations for handling and processing the biological specimens [2].
From the first publication of pathological findings in COVID-19 tissues in March 23 [3] until June 2021, we gathered 36 papers including case reports, case series and letters to the editor from different electronic databases. There is urgency to introduce new knowledge among the scientific community to provide supportive evidence for clinical decisions; However, it has also been argued that safety precautions and overload of work in care units hamper the efforts to collect tissues for more pathological studies [4].
We present a case series of postmortem biopsies from COVID-19 patients and a literature review of the pathological changes described in previous reports.
Eighteen deceased patients diagnosed with COVID-19 and treated at the Naval Medical Center, in Lima, Peru were included in the study. In all cases, a percutaneous biopsy without ultrasound guidance was performed within 2 hours post-mortem, between April 22nd and May 7th, 2020.
Our main goal was to obtain tissue from lungs, heart and liver; however, in obese patients the procedure was limited. Information corresponding to age, sex, duration of symptoms, test used for diagnosis, length of hospitalization, pulmonary CT scan, values of Ferritin and D-Dimer, and comorbidities was extracted from the medical records. In cases with more than one value of Ferritin and/or D-dimer, we chose the highest value (Table 1).
Table 1: Clinical and laboratory data. View Table 1
Tissues were studied with H & E stain and immunohistochemistry with CD3 (Bio SB, clone RBT), CD20 (Bio SB, clone L26), CD68 (Bios SB, clone KP-1), Cytokeratin 7 (Bio SB, clone OY-TL12/30), TTF-1 (Bio-SB, clone 8G7G3/1), and CD61 (Bio SB, Clone F2F). Immunohistochemistry was performed in 5 um sections embedded in paraffin, with antigen retrieval solution at 95 °C for 30´, and using the BIO SB Mouse/Rabbit DAB HRP Brown Polydetector system®.
The biopsies were collected during the first wave of COVID-19 and were aimed to obtain relevant information with clinical application in moments when little data was available. According to two documents published by the WHO, informed consent can be waived for research in the setting of a pandemic [5,6]. Based on these documents, the Ethical Committee of the Naval Medical Center approved the study.
We collected all the papers describing the pathological findings in organ damage by COVID-19 published until June 2021. The sources were PubMed and Google Scholar. Some papers were not included in the review since they did not contain histopathological images and/or detailed pathological descriptions and others due to being published in Chinese language.
Eighteen patients (17 males and 1 female) with a mean age of 65 years were included. The youngest was a 31-year-old man with a previous diagnosis of B-cell leukemia and the oldest was a 91-year-old. Nine patients had a positive molecular test, five were positive for IgM and IgG with the rapid test, one was only IgG positive and another was only IgM positive. In three patients the diagnosis was stablished on the basis of a computed tomography and/or chest X-ray showing atypical pneumonia, after excluding differential diagnoses (Table 1).
All the patients had diffuse alveolar damage (DAD). The microscopic findings associated to DAD were divided by exudative and proliferative phase. 17 patients presented with hyaline membranes and 15 had neutrophilic infiltrates inside alveoli, consistent with the exudative phase of DAD (Table 2).
Table 2: Pathological changes View Table 2
16 cases presented fibroblastic proliferation with dilated interstitial capillaries in the proliferative phase. Squamous metaplasia was found in 7 patients and epithelial hyperplasia in 5 (Table 2).
The most common finding in the heart was perinuclear lipofuscin granules inside myocytes. The content of these granules was confirmed with a positive PAS (Periodic Acid-Schiff) and negative Perl’s staining (Figure 1).
On liver tissue, our patients had dilated sinusoids and erythrocyte congestion. Hepatic steatosis was found in all cases, except one.
36 papers, including as case reports, case series and letters to the editor, described pathological findings from autopsies, postmortem and in vivo biopsies in different organs. They revised in total 615 cases (367 males, 171 females, and 77 cases with no genre specified). 36 studies included lung biopsies and the others described findings in the spleen, kidney and heart.
The most common pathology in the lung was DAD, which was reported in 26 studies. Hyaline membranes and pneumocyte hyperplasia were associated to DAD in many cases [7-11]. Interstitial inflammation with predominant T lymphocytes and bronchial squamous metaplasia were also described [8,12].
Viral particles inside pneumocytes and renal cells were found in electron microscopy, however, only Yao, et al. and Borczuk, et al. confirmed SARS-CoV-2 origin of the particles using IHC [13,14].
Several studies reported thrombotic events in lungs, heart, kidney and spleen. In the lung, 14 studies found microthrombi in alveolar capillaries and arterioles. Other findings were intra-alveolar fibrin and fibrinous exudates.
Only two studies performed biopsies in living patients. Tian, et al. reported incidental findings in two patients with pulmonary resections for lung cancer who, inadvertently, contracted COVID-19 infection just before lung surgery [15]. The other study was performed on kidney biopsies by Ferlicot, et al., who described collapsing glomerulopathy and immunoglobin deposits, acute tubular injury (ATI) and interstitial lymphocytic inflammation [16-18].
The renal findings described by Ferlicot, et al. were similar with the reported in postmortem studies. The most frequent pathologies in the kidneys were ATI with tubular cell atrophy and collapsing glomerulopathy associated with loss of podocyte foot processes [17-20].
Table 3 summarizes the information from the papers included in this review.
Table 3: Reviews describing pathological findings in covid-19 positive case. View Table 3
In this study, we described the microscopic features found in autopsies from 18 patients who died from SARS-CoV-2 infection at the beginning of the pandemic in the Naval Medical Center located in Lima, Peru. All but one of our cases were males, which is an unusual finding in a third-level hospital that covers a population of both men and women at all ages.
In 9 of our cases, the diagnosis was confirmed with a positive PCR for SARS-CoV-2 and in 7 patients, serologic testing was used. In 3 patients, the diagnosis was made based on the clinical symptoms and a CT scan. These patients could not access to a molecular or rapid testing due to the scarcity of specific testing for Covid-19 at the time of diagnosis. In the setting of a world pandemic, the positive predictive value of a CT scan for diagnosing Covid-19 infection is 69% and the negative predictive value is 89% [21]. For this reason, the 3 cases were included in our series.
We performed a literature review and contrasted our findings with the current literature. The majority of studies describing pathological changes associated with COVID-19 infection have focused on the lungs. To the best of our knowledge, there are 36 postmortem studies and only 1 study [15] describing the pathological findings in lung tissue from alive patients. The study on fresh tissue presented changes reported in the majority of postmortem studies and not related to death. These changes included: diffuse alveolar damage [10,12,14,22-26] alveolar proteinaceous exudates, vascular congestion [11,12,27] lymphocytic inflammatory infiltrates [8,11,13,23,24,28] hyaline membranes [7,9,12,20,24,26,28-33] and intraalveolar fibrin with mononuclear and giant multinucleated cells [7], pneumocyte hyperplasia [7-11,14,15,24,25,28,33-35] alternating zones of exudative and proliferative phases of DAD, and suspected viral inclusions [7,20,22,36,37] (Table 3). Other pathological changes were thrombosis of small lung arteries [13,15], squamous metaplasia [12,24], bronchopneumonia [12,20], spherical secretions or globules [7], and megakaryocytes [22,31]. Using immunohistochemistry and electron microscopy, viral particles of coronavirus were found in type II pneumocytes, and cylindrical epithelia from the bronchioles [13], which correlates with the cytopathic changes found with H&E.
In our cases, we observed markedly congested vessels (Figure 1), and prominent DAD with coexistence of exudative and proliferative phases in most patients (Figure 2 and Figure 3). In the periphery of the more compromised areas, the presence of alveolar microthrombi was striking. The immunohistochemistry with TTF-1 highlighted the hyperplasia of atypical type II pneumocytes (Figure 4); and with CK7 collapsed alveoli were surrounded by a fibroblastic proliferation (Figure 5). As it was observed by others, we found scant inflammatory infiltrates in the majority of cases, but those complicated by bronchopneumonia (Figure 6). We also found giant multinucleated cells, which were positive to CK7, and had cytopathic-like changes in the majority of cases (Figure 7). The cytopathic-like changes consisted of large nuclei, nucleolar inclusions, lumpy chromatin, and a large, eosinophilic cytoplasm; however, these changes are not specific for Sars-cov-2, therefore they cannot be used as diagnostic criteria for COVID-19 pneumonia. Variable amounts of CD68 positive alveolar macrophages were identified (Figure 8). Interestingly, higher amounts of alveolar macrophages were observed in patients with the highest values of ferritin (observation not systematized). This finding correlates with the role of ferritin in macrophage activation and the proposal to include COVID-19 within the hyperferritinemic syndromes [38].
 Figure 1: Section of a heart showing perinuclear lipofuscin granules (PAS staining).
View Figure 1
Figure 1: Section of a heart showing perinuclear lipofuscin granules (PAS staining).
View Figure 1
 Figure 2: Prominent DAD with coexistence of exudative and proliferative phases.
View Figure 2
Figure 2: Prominent DAD with coexistence of exudative and proliferative phases.
View Figure 2
 Figure 3: The immunohistochemistry with TTF-1 highlighted the hyperplasia of atypical type II pneumocytes.
View Figure 3
Figure 3: The immunohistochemistry with TTF-1 highlighted the hyperplasia of atypical type II pneumocytes.
View Figure 3
 Figure 4: Hyaline membranes with atypical pneumocytes (HE,40X).
View Figure 4
Figure 4: Hyaline membranes with atypical pneumocytes (HE,40X).
View Figure 4
Figure 5: DAD early proliferative phase (HE,40X).
View Figure 5
Figure 5: DAD early proliferative phase (HE,40X).
View Figure 5
 Figure 6: CK7 in an area of proliferative phase of DAD (40X).
View Figure 6
Figure 6: CK7 in an area of proliferative phase of DAD (40X).
View Figure 6
 Figure 7: Neutrophilic exudate within alveoli in a patient complicated with bronchopneumonia (HE,40X).
View Figure 7
Figure 7: Neutrophilic exudate within alveoli in a patient complicated with bronchopneumonia (HE,40X).
View Figure 7
 Figure 8: Hyaline membranes and a multinucleate atypical cell (HE,40X).
View Figure 8
Figure 8: Hyaline membranes and a multinucleate atypical cell (HE,40X).
View Figure 8
The immunohistochemistry with CD61 showed platelets and megakaryocytes forming aggregates within vessels in the alveolar septa (Figure 9), similar to the findings by Dohlnikoff, Carsana and Fox [22,24,31]. We found large megakaryocytes inside vessels, which was not considered of diagnostic importance, as the lungs are a reservoir of these cells [39].
 Figure 9: CD68 depicting alveolar macrophages (40X).
View Figure 9
Figure 9: CD68 depicting alveolar macrophages (40X).
View Figure 9
The most common finding in heart tissue our heart sample was aggregates of large brown vacuoles filled with lipofuscin, located at the poles of the nuclei in tshe cardiomyocytes (Figure 10 and Figure 11). Deposition of lipofuscin is considered normal as a part of the aging process [39]; however, it calls to our attention that the amounts observed surpass what is expected in aging organs, especially in our six patients younger than 60-years-old. We hypothesize that the origin of these deposits is related to the cardiotoxicity of hydroxychloroquine, as all the patients in our study received cumulative doses from 0.8 to 7.6 g (400 mg/day) of hydroxychloroquine. Our dose is similar to the one used by Lane, et al. who showed an increased risk of heart disease in hydroxychloroquine users [40]. The accumulation of lysosomes with lipofuscin has been previously reported in two patients with cardiac toxicity due to hydroxychloroquine, but the dose was not specified [41].
 Figure 10: CD61 showing megakaryocytes (large dots) and aggregates of platelets (small dots) (40X).
View Figure 10
Figure 10: CD61 showing megakaryocytes (large dots) and aggregates of platelets (small dots) (40X).
View Figure 10
 Figure 11: Section of the heart showing deposits of a paranuclear light-brown material (HE,40X)..
View Figure 11
Figure 11: Section of the heart showing deposits of a paranuclear light-brown material (HE,40X)..
View Figure 11
Other findings associated to chronic toxicity of chloroquine (cytoplasmic vacuolization with inclusions of PAS positive granular material), were not identified in our cases. It is important to point out that none of the patients died as a result of cardiac dysfunction. Also, no significant electrocardiographically alterations were observed in any of the patients during hospitalization, even in the patient with myocardial microabcesses.
Other possible cause of lipofuscin in the heart is the oxidative damage caused by SARS-CoV-2 virus in multiple organs. S protein in the viral capsule induces the production of reactive oxygen species (ROS) through stimulation of NAPDPH oxidase [42]. Neutrophils are another source of ROS in covid-19 infection, especially in earlier stages of the disease [43]. These cells have been identified in myocardium tissue from infected patients [12,23,31], which would suggest that the heart is a target of the viral infection.
The findings in the liver, such as steatosis, sinusoidal dilatation and congestion (Figure 12), were found in the majority of cases. Mild inflammation was found in some cases and could be associated to preexisting comorbidities, drug effects, and/or unspecific systemic changes, as it has been pointed out by other authors [15,23].
 Figure 12: Another heart with similar light-brown aggregate (HE,100X).
View Figure 12
Figure 12: Another heart with similar light-brown aggregate (HE,100X).
View Figure 12
In summary, our findings corroborate the histological injury in the lungs as previously reported. A larger number of alveolar macrophages were found in the cases with the highest values of ferritin. We also found aggregates of lipofuscin in all the hearts examined, probably in association with therapy with hydroxychloroquine.